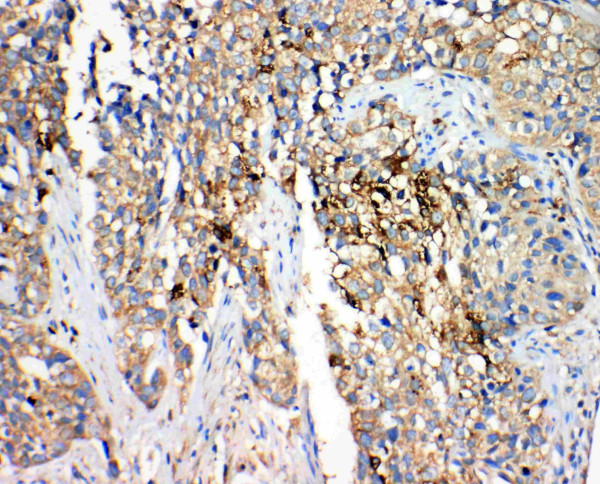
Anti-17 beta HSD 4

Cookie preferences
This website uses cookies, which are necessary for the technical operation of the website and are always set. Other cookies, which increase the comfort when using this website, are used for direct advertising or to facilitate interaction with other websites and social networks, are only set with your consent.
Configuration
Technically required
These cookies are necessary for the basic functions of the shop.
"Allow all cookies" cookie
"Decline all cookies" cookie
CSRF token
Cookie preferences
Currency change
Customer-specific caching
FACT-Finder tracking
Individual prices
Selected shop
Session
Comfort functions
These cookies are used to make the shopping experience even more appealing, for example for the recognition of the visitor.
Note
Show the facebook fanpage in the right blod sidebar
Statistics & Tracking
Affiliate program
Conversion and usertracking via Google Tag Manager
Track device being used
| Item number | Size | Datasheet | Manual | SDS | Delivery time | Quantity | Price |
|---|---|---|---|---|---|---|---|
| ARG58811.50 | 50 µg | - | - |
6 - 14 business days* |
551.00€
|
If you have any questions, please use our Contact Form.
You can also order by e-mail: info@biomol.com
Larger quantity required? Request bulk
You can also order by e-mail: info@biomol.com
Larger quantity required? Request bulk
Protein function: Bifunctional enzyme acting on the peroxisomal beta- oxidation pathway for fatty... more
Product information "Anti-17 beta HSD 4"
Protein function: Bifunctional enzyme acting on the peroxisomal beta- oxidation pathway for fatty acids. Catalyzes the formation of 3- ketoacyl-CoA intermediates from both straight-chain and 2-methyl- branched-chain fatty acids. [The UniProt Consortium]
| Keywords: | Anti-EDH17B4, Anti-HSD17B4, EC=4.2.1.107, EC=4.2.1.119 |
| Supplier: | Arigo Biolaboratories |
| Supplier-Nr: | ARG58811 |
Properties
| Application: | IHC (paraffin) |
| Antibody Type: | Polyclonal |
| Conjugate: | No |
| Host: | Rabbit |
| Species reactivity: | human (Expected: mouse, rat, hamster) |
| Immunogen: | Synthetic peptide corresponding to aa. 744-761 of Human 17 beta HSD 4 (NIMLSQKLQMILKDYAKL) |
| MW: | 80 kD |
| Format: | Antigen Affinity Purified |
Database Information
| KEGG ID : | K12405 | Matching products |
| UniProt ID : | P51659 | Matching products |
| Gene ID : | GeneID 3295 | Matching products |
Handling & Safety
| Storage: | -20°C |
| Shipping: | +4°C (International: °C) |
Caution
Our products are for laboratory research use only: Not for administration to humans!
Our products are for laboratory research use only: Not for administration to humans!
Information about the product reference will follow.
more
You will get a certificate here
Viewed